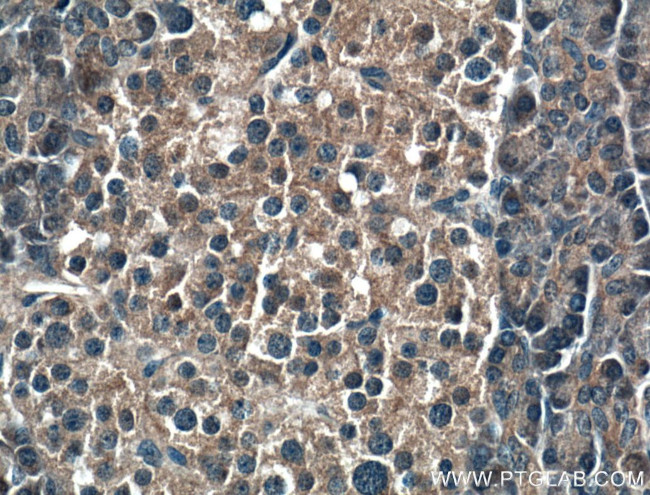
RIC8A Antibody in Immunohistochemistry (Paraffin) (IHC (P))

Search
Proteintech
RIC8A Monoclonal Antibody (1E3B11)
{{$productOrderCtrl.translations['antibody.pdp.commerceCard.promotion.promotions']}}
{{$productOrderCtrl.translations['antibody.pdp.commerceCard.promotion.viewpromo']}}
{{$productOrderCtrl.translations['antibody.pdp.commerceCard.promotion.promocode']}}: {{promo.promoCode}} {{promo.promoTitle}} {{promo.promoDescription}}. {{$productOrderCtrl.translations['antibody.pdp.commerceCard.promotion.learnmore']}}
产品信息
66625-1-IG
种属反应
宿主/亚型
分类
类型
克隆号
抗原
偶联物
形式
浓度
规格
纯化类型
保存液
内含物
保存条件
运输条件
产品详细信息
Immunogen sequence: QQLFQELKG VRLLTDTLEL TLGVTPEGNP PTLLPSQETE RAMEILKVLF NITLDSIKGE VDEEDAALYR HLGTLLRHCV MIATAGDRTE EFHGHAVNLL GNLPLKCLDV LLTLEPHGDS TEFMGVNMDV IRALLIFLEK RLHKTHRLKE SVAPVLSVLT ECARMHRPAR KFLKAQVLPP LRDVRTRPEV GEMLRNKLVR LMTHLDTDVK RVAAEFLFVL CSESVPRFIK YTGYGNAAGL LAARGLMAGG RPEGQYSEDE DTDTDEYKEA KASINPVTGR VEEKPPNPME GMTEEQKEHE AMKLVTMFDK LSRNRVIQPM GMSPRGHLTS LQDAMCETME QQLSSDPDSD PD (117-467 aa encoded by BC011821)
靶标信息
Guanine nucleotide exchange factor (GEF), which can activate some, but not all, G-alpha proteins. Able to activate GNAI1, GNAO1 and GNAQ, but not GNAS by exchanging bound GDP for free GTP. Involved in regulation of microtubule pulling forces during mitotic movement of chromosomes by stimulating G(i)-alpha protein, possibly leading to release G(i)-alpha-GTP and NuMA proteins from the NuMA-GPSM2-G(i)-alpha-GDP complex. Also acts as an activator for G(q)-alpha (GNAQ) protein by enhancing the G(q)-coupled receptor-mediated ERK activation.
仅用于科研。不用于诊断过程。未经明确授权不得转售。
篇参考文献 (0)
生物信息学
蛋白别名: Chaperone Ric-8A; heterotrimeric G protein guanine nucleotide exchange factor Ric-8A; MGC104517; MGC131931; MGC148073; MGC148074; resistance to inhibitors of cholinesterase 8 homolog; resistance to inhibitors of cholinesterase 8 homolog A; resistance to inhibitors of cholinesterase 8A; RIC8 protein; synembryn; Synembryn-A; unnamed protein product
基因别名: AI114950; RIC-8; Ric-8A; RIC8; RIC8A
UniProt ID: (Human) Q9NPQ8, (Mouse) Q3TIR3, (Rat) Q80ZG1
Entrez Gene ID: (Human) 60626, (Mouse) 101489, (Rat) 293614